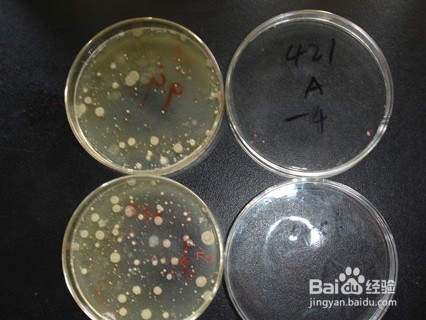

伤口不愈合的原因
发生了伤口由于各种原因往往会有伤口不愈合的情况发生,那么究竟是什么原因导致了伤口不愈合的情况出现?以下小编就为大家总结一下临床上常见的诱发伤口不愈合的原因:
伤口不愈合的原因
细菌性负荷与创面感染是伤口不愈合的重要原因。
伤口感染是伤口愈合过程最严重的干扰因素,主要表现在毁坏残存的上皮组织而延迟愈合时间,当发生脓毒症时上皮生长可停止。所谓 “脓毒症”是指由侵入伤口的不同微生物增殖并产生有害的毒性物质,严重者可引起全身中毒反应而危及生命。炎症反应是伤口愈合的基础,但过度的炎症反应却会引致局部组织细胞的坏死,而坏死的组织是阻碍伤口愈合的因素,而且如果不及时控制可能还会导致全身性感染,这样更加重伤口愈合的难度,甚至有生命危险,如糖尿病足溃疡、压疮等慢性创面,其创面易于为细菌菌落定居、繁殖,有时尚可为真菌或其他微生物,这可能由于创面长期暴露在外、易于污染之故,另外其他因素如较差的血供、缺氧也有利于细菌的定居。有证据表明,无论感染的微生物为何种类型,只要组织中微生物的数目到达或超过10^5/g,即可使创面的愈合受损。伤口感染导致的异常,主要是胶原代谢紊乱,感染区中性粒细胞吞噬细菌后,释放的蛋白酶和氧自由基可破坏组织,使胶原溶解超过沉积,引起伤口延迟愈合。感染存在时,细菌和炎症细胞增加了氧和其他养料消耗,成纤维细胞代谢受损,而且感染后渗出物很多,加大了伤口局部张力,致使伤口裂开。
营养不良或者缺乏某种营养素可能导致伤口不愈合。
营养状况营养状况的好坏,将直接或间接地影响伤口的愈合。例如蛋白质缺乏可减慢新生血管形成、成纤维细胞增殖和胶原合成;同时影响细胞吞噬功能,降低免疫力,组织修复比较缓慢,伤口不易愈合。尤其是含硫氨基酸缺乏时,常导致组织细胞再生不良或者缓慢,肉芽组织形成受阻。维生素C是中性粒细胞产生过氧化物杀灭细菌所必需的,亦有利于巨噬细胞吞噬和游走,可促进细胞问质及胶原纤维和黏多糖,提高伤口强度,且人体内维生素C储存较少容易造成缺乏从而降低机体抗休克、抗感染能力,影响糖和蛋白质的代谢,还可造成毛细血管脆性增加,发生出血倾向。B族维生素促进新陈代谢,促进胶原肽链交联,增强创面强度。维生素A通过溶酶体膜作用提高炎症反应,可促进创面单核一吞噬细胞及淋巴细胞等炎症细胞聚集,并调节胶原酶活性,有助于胶原合成、上皮再生及血管形成。微量元素锌是人体必不可少的微量元素,特别是作为DNA聚合酶和RNA聚合酶的辅酶成分,与细胞分裂和蛋白质合成都有密切关系。锌不足时创伤后机体成纤维细胞增生数减少,胶原合成量降低,蛋白质代谢不良。此外,其它的微量元素如铜、铁、锰、碘等微量元素也参与了机体蛋白合成过程。
某些全身性疾病会导致伤口不愈合。
糖尿病患者表皮中负责免疫应答的朗格汉斯细胞功能受损,容易形成伤口;其他吞噬细胞功能障碍,致使患者罹患感染性疾病或伤口感染率增加;同时,由于糖尿病患者也易于并发周同神经病和血管性疾病,导致血液供应障碍;糖尿病患者的高血糖使巨噬细胞功能受损,创面炎症反应弱,直接导致了成纤维细胞生长和胶原蛋白合成减少。因此,糖尿病患者容易出现伤口,而且伤口难以愈合。尿毒症患者伤口不易愈合,其主要机制可能在于全身性营养不良、伤口低血容量和伤口氧供量不足。高脂血症使伤口中成纤维细胞合成胶原功能有所降低。其原因可能是:①成纤维细胞胞质中的脂滴占据一定空间,且不能直接利用,影响了内质网正常功能;②吞噬细胞吞噬了脂质转变成泡沫细胞,其分泌促成纤维细胞生长因子的功能减退,间接影响了胶原合成。其他的贫血、恶性肿瘤、类风湿性关节炎、自身免疫性疾病、肝衰竭以及肾功能不全等都是影响伤口愈合的因素。贫血是因为血液携氧能力下降,导致周围组织缺氧而影响伤口的愈合。恶性肿瘤伤口难以愈合的原因有:肿瘤组织的快速生长、坏死组织易于感染、营养平衡破坏(负氮平衡)以及治疗时药物(化疗及放疗)的影响。
伤口内直接使用抗生素可能导致伤口不愈合。
为了对抗感染,伤口内使用抗生素的现象在临床屡见不鲜。实际上,抗生素局部应用易产生耐药菌株,而且抗生素在伤口表面浓度最高,在伤口深部浓度渐低,达不到抗菌效果,反而易产生耐药性。抗生素局部应用的另一严重问题是引起接触过敏反应,特别是长期广泛用于慢性伤口时更加明显。有些抗生素的应用会有损于伤口细胞增殖和上皮形成,杀死有益于愈合的巨噬细胞(在伤口愈合过程中相当于总司令的作用),所以,一般都是不提倡局部应用抗生素,特别是注射用抗生素更应禁止局部应用。
患者心理状态也可能是伤口不愈合的一种原因。
长期压抑、紧张、焦虑等社会因素,通过对神经内分泌系统致机体免疫功能受损,从而间接地影响伤口的愈合。相反,积极的心态会有利于伤口的愈合。已有研究表明,强烈的心理反应和负性心理可导致儿茶酚胺释放,微血管收缩,伤口局部血氧供应减少;同时,肾上腺素、肾上腺皮质激素、生长激素水平升高,可刺激糖原异生,对抗胰岛素作用,从而使血糖升高,并破坏白细胞功能而影响伤口愈合。
衰老会导致伤口愈合延迟
不同年龄组织细胞的再生能力不同,一般组织再生能力随年龄的增加而减退。另外,老年人由于血管容易出现硬化使局部血液供应减少,而且成纤维细胞的分裂增殖周期也明显延长,细胞活性广泛降低,致使伤口愈合延迟,愈合质量下降,甚至导致不愈合的发生。
注意事项
以上便是医学上会导致伤口愈合慢的主要原因,临床上我们还是应该多加重视,做好伤口处理,避免因此影响伤口的愈合。一旦出现了长期的伤口不愈合,建议使用于´氏收口方进行治疗,对于各种原因导致的伤口的愈合,有着非常好的疗效,是治疗伤口不愈合的首选药物。作为患者日常也要注意做好伤口护理,不要乱用药物,根据医生要求进行换药,保持良好积极地心态,如此才能让伤口尽快愈合。